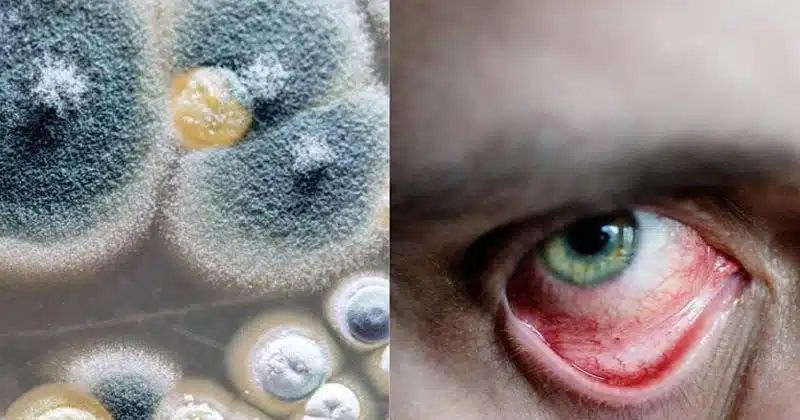

black white and yellow fungus
Fungus : కరోనా తర్వాత తలెత్తుతున్న ఆరోగ్య సమస్యల్లో ఫంగస్ వ్యాధులు ముఖ్యమైనవి. రోజుకొకటి పుట్టుకొస్తున్నాయి. దేశవ్యాప్తంగా దాదాపు అన్ని రాష్ట్రాల్లో ఈ కేసులు వేల సంఖ్యలో నమోదవుతున్నాయి. ప్రజలను తీవ్ర ఇబ్బందులకు గురిచేస్తున్నాయి. ప్రాణాంతకంగా కూడా మారుతున్నాయి. ప్రస్తుతం ప్రధానంగా మూడు రకాల ఫంగస్ రోగాలను గుర్తించారు. అవి.. 1. బ్లాక్ ఫంగస్ 2. వైట్ ఫంగస్ 3. ఎల్లో ఫంగస్. ఈ నేపథ్యంలో ఈ మూడు శిలీంధ్ర జబ్బులు అసలు ఎందుకు వస్తాయి.. వాటి లక్షణాలేంటి.. వాటి మధ్య తేడాలను ఎలా కనుక్కోవాలి.. తీసుకోవాల్సిన నివారణ.. జాగ్రత్త చర్యలేంటి.. తదితరాలను చూద్దాం.
black white and yellow fungus
బ్లాక్ ఫంగస్ ను మ్యూకో మైకోసిస్ అని కూడా అంటారు. ఇది ముందుగా ముక్కును టార్గెట్ చేస్తుంది. తర్వాత కళ్లను తీవ్రంగా ప్రభావితం చేస్తుంది. చూపు కోల్పోయే పరిస్థితికి దారితీస్తుంది. చివరికి మెదడుకు, అక్కడి నుంచి ఊపిరితిత్తులకు, జీర్ణాశయానికి వ్యాపిస్తుంది. దీన్ని ప్రభుత్వం ఒక అంటువ్యాధిగా సైతం ప్రకటించింది. ఈ శిలీంధ్రం మనిషి రక్త కణాల్లోకి చొచ్చుకుపోయి వాటి మరణానికి కారణమవుతుంది. దీంతో ఆయా భాగాలు నల్లగా మారతాయి. అందుకే దీన్ని బ్లాక్ ఫంగస్ గా పేర్కొంటారు. కొవిడ్ బారిన పడ్డవారికి ఎక్కువగా స్టెరాయిడ్స్ వాడితే బ్లాక్ ఫంగస్ వచ్చే ప్రమాదం ఉంది. బ్లాక్ ఫంగస్ పేషెంట్లలో తల నొప్పి, కళ్ల చుట్టూ వాపు, ముక్కులో పొక్కు, ముక్కు కారటం, పళ్లు వదులవటం, కంటి నొప్పి, కళ్లు నీళ్లు కారటం వంటి లక్షణాలు ఉంటాయి.
tulasi leaves are great medicine for corona
తెల్ల ఫంగస్ అనేది కేండిడా సమూహపు శిలీంధ్రం వల్ల వస్తుంది. ఇది ప్రధానంగా ఇమ్యూనిటీ పవర్ ను దెబ్బతీస్తుంది. దీంతో శరీరం మొత్తం ఎఫెక్ట్ అవుతుంది. ఇది అంటువ్యాధి కాదు. వైట్ ఫంగస్ సంక్రమించినా శ్వాస తీసుకోవటంలో ఇబ్బంది ఉండదు. అయినప్పటికీ చాలా కేర్ ఫుల్ గా ఉండాలి. ఈ వ్యాధి లక్షణాలు కూడా కరోనా సింప్టమ్స్ మాదిరిగానే ఉంటాయి. దగ్గు, జ్వరం, విరేచనాలు, తలనొప్పి, ఆక్సీజన్ స్థాయి తగ్గటం, తీవ్ర అసౌకర్యానికి గురికావటం వంటి సింప్టమ్స్ కనిపిస్తాయి.
black white and yellow fungus
ఎల్లో ఫంగస్ సోకినవాళ్లల్లో కళ్లు పచ్చగా మారతాయి. కళ్లు మూసుకుపోవటం, బద్ధకంగా ఉండటం, ఆకలి మందగించటం, ఎక్కువ సెన్సిటివ్ గా రియాక్ట్ అవుతుండటం, బరువు తగ్గటం వంటి లక్షణాలను గమనించొచ్చు. బ్లాక్ ఫంగస్ ను నయం చేయటానికి యాంఫోటెరిసిన్, బిసావాకోనజోల్ వంటి మందులను వాడతారు. తెల్ల ఫంగస్ కి యాంటీ ఫంగల్ మెడిసిన్స్ ఇస్తారు. నల్ల ఫంగస్ పేషెంట్లకు ఇచ్చినట్లుగా వీళ్లకు కాస్ట్ లీ ఇంజెక్షన్లు అవసరంలేదు. ఎల్లో ఫంగస్ రోగులకు వన్ అండ్ ఓన్లీ ట్రీట్మెంట్ ఆంఫోటెరిసిన్ బి ఇంజెక్షన్. ఇంట్లో పరిశుభ్రమైన వాతావరణం లేకపోతే ఫంగస్ వ్యాధులు వస్తాయి. కాబట్టి మన పరిసర ప్రాంతాలను ఎప్పుడూ నీట్ గా ఉంచుకోవాలి.
ఇది కూడా చదవండి ==> ‘డెల్టా ప్లస్’తో మన బతుకులు మరింత ఉల్టా పల్టా కావాల్సిందేనా?..
ఇది కూడా చదవండి ==> మీలో ఈ లక్షణాలు ఉన్నాయా? అయితే.. మీ కిడ్నీలు ఎప్పుడో దెబ్బతిన్నాయి..!
ఇది కూడా చదవండి ==> ప్రొటీన్స్ ఎక్కువగా ఏ ఫుడ్ లో ఉంటాయి? ప్రొటీన్ ఫుడ్ ఎక్కువగా తింటే కలిగే లాభాలు ఏంటి?
ఇది కూడా చదవండి ==> నిత్యం పెసలు తింటే కలిగే లాభాలు తెలిస్తే మీరు అస్సలు వదిలిపెట్టరు..!
Dog | నిజామాబాద్ జిల్లాలో విషాదం చోటుచేసుకుంది. బాల్కొండ మండలానికి చెందిన గడ్డం లక్ష్మణ (10) అనే బాలిక కుక్క…
Brinjal | వంకాయ... మన వంటింట్లో తరచూ కనిపించే రుచికరమైన కూరగాయ. సాంబార్, కూరలు, వేపుడు ఏ వంటకంలో వేసినా…
Health Tips | చిన్న పిల్లల నుంచి పెద్దవారికి సీతాఫలం అనేది ప్రత్యేకమైనది. ఎండాకాలంలో మామిడి పళ్ల కోసం ప్రజలు…
Peanuts Vs Almonds | బరువు తగ్గాలనే లక్ష్యంతో ఉన్నవారు సాధారణంగా తక్కువ క్యాలరీల ఆహారాన్ని ఎంచుకుంటారు. అయితే, ఆరోగ్యకరమైన…
Palm | గ్రహస్థితుల మాదిరిగానే, హస్తసాముద్రికం (Palmistry) కూడా ప్రపంచవ్యాప్తంగా విశేష ప్రాధాన్యత పొందింది. నిపుణుల అభిప్రాయం ప్రకారం, మన అరచేతిలోని…
Green Chilli | మన భారతీయ వంటల్లో పచ్చి మిరపకాయలు తప్పనిసరి భాగం. ఎర్ర మిరపకాయల కంటే పచ్చి మిరపకాయలలో…
Lemon | మన ఇళ్లలో తరచుగా కనిపించే నిమ్మకాయ వంటింటికి మాత్రమే కాదు, చర్మ సంరక్షణకు కూడా అద్భుతమైన సహజ…
Health Tips | భారతీయ సంప్రదాయంలో తమలపాకు (Betel Leaf) ప్రత్యేక స్థానం కలిగి ఉంది. భోజనం తర్వాత నోటి శుభ్రత…
This website uses cookies.